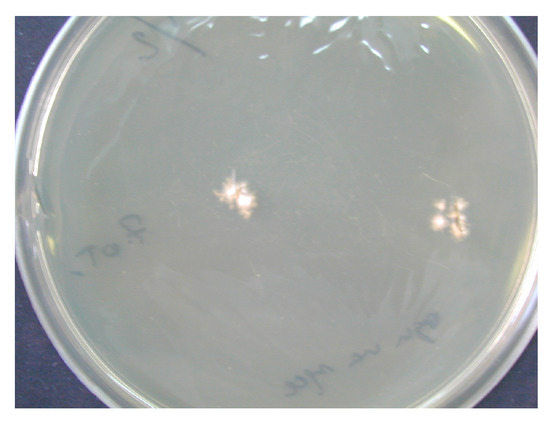

Abstract
Dermatophytosis in cattle is most often caused by infection with Trichophyton verrucosum (T. verrucosum), but also with Trichophyton rubrum (T. rubrum), Trichophyton mentagrophytes (T. mentagrophytes) and others, regardless of the geographical zone. The infection is transmitted through direct contact between animals as well as infected environmental elements. The human-to-human transmission of fungal infection is also possible.. This retrospective study was conducted based on a detailed analysis of the results of the mycological examination and medical documentation of 40 patients from Greater Poland, diagnosed with cattle-to-human dermatophytoses from March 2017 to November 2023. T. verrucosum accounted for 97.5% of infections and T. mentagrophytes for 2.5%; no other species of dermatophytes from cattle were found. Superficial skin mycosis in humans associated with cattle was more often diagnosed in small children and men directly engaged in cattle breeding. The dominant etiological factor of the superficial fungal skin infection was T. verrucosum, which mainly affected the scalp in children and upper limbs in adult men. In relation to the cattle population in Greater Poland, the number of cases of superficial skin mycoses among cattle breeders and their family members over the period of more than six and a half years of observation does not seem to be high.
1. Introduction
Cattle population worldwide amounted to 940.37 million heads in 2022, and it has been on an increasing trend since 2019 [1]. The list of letter codes for cattle breeds includes 64 breeding breeds [2]. The number of cattle has fluctuated over the reported period between 1950 and 2022 in Poland, showing an increasing trend in beef cattle and downward trend in dairy cattle since 2016 [3]. In December 2023, the cattle population in Poland was 6,435.5 thousand, including 2,203.9 thousand cows. According to the Polish Central Statistical Office, in December 2023, the cattle population in Greater Poland amounted to almost 1,152 thousand units [4]. The vast majority of cattle breeding farms in Greater Poland are medium-sized and large family farms.
Dermatophytes causing diseases in animals and posing a threat to humans belong to the genera Epidermophyton, Microsporum, Nannizzia, Trichophyton and almost 40 other species [5]. Dermatophytosis in cattle is most often caused by infection with T. verrucosum, but also with T. rubrum, T. mentagrophytes and Trichophyton simii (T. simii) or Nannizzia gypsea (N. gypsea) regardless of geographical zone [6,7]. T. verrucosum is less common in horses and small ruminants such as sheep and goats, as well as in llamas and camels [7,8,9,10].
Calves aged 1–6 months, regardless of gender and breed, get sick more often than adults because they have not yet developed natural specific immunity to fungi. However, they have high skin PH [6,11,12,13]. The infection is transmitted through direct contact between animals and through infected environmental elements such as brushes, gates, feed carts, farm tools and employees, and others or through asymptomatic carriers. Inappropriate sanitary conditions, high animal concentration, frequent animal regrouping, high humidity and the temperature of cowsheds, and also, malnutrition, changes in diet, immune and vitamin deficiencies or parasitic infections and intensive use of corticosteroids contribute to the spread of the infection [13,14]. An additional factor that allows and favors the spore formation and transmission of infection is the hot and humid climate in some countries. In countries with temperate climate, the peak of infection usually occurs in summer and winter [12,15]. A connection of an increased number of fungal skin infections with a humid oceanic climate, rainy years, and an autumn and winter period, when animals are confined indoors, has also been observed [16,17]. Spores can persist in the environment for up to several years and be a potential source of infection [18]. Therefore, knowledge of the local epidemiology of dermatophytes is important for the mycologist when identifying fungi and for the physician [16]. Superficial zoonotic mycosis in humans results from direct contact with infected cattle or elements of the animal environment, and can also be transferred from human to human [13,19,20]. Clinical manifestations, methods of diagnosis, treatment, and prevention of dermatophyte infections in cattle and humans are included in Table 1.

Table 1.
Clinical manifestation, diagnosis, treatment, and prevention of dermatophytosis in cattle and humans.

Figure 3.
Clinical picture of glabrous skin mycosis caused by T. verrucosum infection (courtesy of Honorata Kubisiak-Rzepczyk).

Figure 2.
Ringworm of the scalp caused by T. verrucosum (courtesy of Honorata Kubisiak-Rzepczyk).

Figure 1.
Skin lesions in the course of T. verrucosum infection observed in cattle.
Table 1.
Clinical manifestation, diagnosis, treatment, and prevention of dermatophytosis in cattle and humans.
| Cattle | Humans | |
|---|---|---|
| Clinical Manifestations |
|
|
| Diagnosis |
|
|
| Treatment |
|
|
| Prevention |
|
|
The aim of the study was to identify superficial zoonotic mycosis infections in humans directly or indirectly associated with cattle breeding, to determine dermatophyte species derived from cattle and the location of the infection in relation to the age of the patients.
2. Materials and Methods
This retrospective study was conducted based on a detailed analysis of the results of the mycological examination and medical documentation of 40 patients from Greater Poland, diagnosed with cattle-to-human dermatophytosis in the Medical Mycology Laboratory of the Department of Dermatology and Venereology at the Poznan University of Medical Sciences (PUMS) from March 2017 to November 2023. The mycological diagnostics consisted of detecting fragments of fungal structures directly from the material collected from the patient and fully identifying the etiological factor. The detailed procedures followed depended on the location of the skin lesions, the type of material examined, and the suspected etiological factor.
The diagnostic material consisted of the following:
- −
- Epidermal scales scraped off with a surgical curette or scalpel from the periphery of the fungal lesions;
- −
- Covers of blisters or vesicles and swabs from under the cover and deep swabs from the diseased places;
- −
- Hair with bulbs from the center of the lesion, taken with tweezers;
- −
- Swabs of pus taken with a dry, sterile brush.
The improper collection of material may cause false-negative results of mycological examination. There was no fluorescence of disease lesions in the light of a Wood’s lamp. From some of the collected diagnostic material, preparations were performed for direct microscopic examination. The material was treated with 10–20% KOH with the addition of 40% DMSO (dimethyl sulfoxide) and examined in a light or phase-contrast microscope at 200- and 400-fold magnification, looking for mycelial hyphae or spores (ZEISS Axio Lab.A1 Microscope and ZEISS Axiocam 105 color Microscope Camera, Carl Zeiss Microscopy GmbH, Jena, Germany). ZEN Microscopy Software 3.9 was used for microscopic imaging and data archiving (Carl Zeiss Microscopy GmbH, Jena, Germany). Additionally, the collected material was treated with Calcofluor and assessed by fluorescence microscopy (characteristic fluorescence of fungal hyphae). The cultivation of the diagnostic material to identify the fungus species was carried out on Sabouraud Dextrose Agar (SDA) (Aura, Zawroty, Poland) with the addition of chloramphenicol and actidione at the temperatures of 25 ℃ and 37 ℃, for a period of 3–6 weeks. The species identification of dermatophytes grown on media was made based on macroscopic and microscopic features visible in the obtained cultures (characteristic hyphae and spores) (Figure 4 and Figure 5). The results are presented as descriptive statistics (ranges and percentages).
Figure 4.
Culture of T. verrucosum on SDA (courtesy of Honorata Kubisiak-Rzepczyk).

Figure 5.
Microscopic examination (magnification ×400) (courtesy of Honorata Kubisiak-Rzepczyk).
3. Results
This study involved 40 people, cattle breeders and their family members, aged from 1 to 75 years. The average age of all patients was 21 years. Children constituted half of the study population. Among them, the largest group consisted of 15 children aged up to 5 years. Men predominated and constituted 60% of the study group (24 patients). In adulthood, dermatophytosis was most often observed between the ages of 31 and 35 (Figure 6).

Figure 6.
Number of patients in particular age groups.
Fungal skin infections in people directly or indirectly involved with cattle breeding were located in various parts of the body. Skin lesions caused by T. verrucosum (Figure 3) were most frequently observed on the head, followed by the trunk, the upper limb, the lower limb and the neck. T. mentagrophytes infection was diagnosed in one case and was found on the scalp, neck and trunk (Figure 7).

Figure 7.
General localization of dermatophytes.
A detailed analysis of skin infections made it possible to determine the frequency of dermatophytes in specific parts of the body. Dermatophytosis was present only in one location in 14 patients. The distribution of skin mycosis in two locations was observed in nine cases, and in three places in the remaining three patients. The most common site of T. verrucosum infection was the stomach, followed by the hairy scalp, back, neck and thigh. Subsequently, less numerous skin lesions caused by this dermatophyte were observed in other parts of the body. T. mentagrophytes diagnosed in one patient was localized on the skin of the cheeks, neck, chest, stomach and back (Table 2).

Table 2.
Detailed distribution of dermatophytes on the skin.
The direct microscopic examination allowed for the identification of structural elements (hyphae and/or spores) in 26 patients (65%) (Figure 8 and Figure 9). A positive T. verrucosum result was found in 25 patients, and T. mentagrophytes was positive in only one case. The microscopic image of T. verrucosum showed microconidia forming chlamydospores in the form of long chains. In the case of T. mentagrophytes infection, microconidia were arranged singly along unbranched hyphae. In order to identify the dermatophyte species, the culture was performed regardless of the direct examination result. T. verrucosum was confirmed in 39 patients (97.5%), and T. mentagrophytes infection was diagnosed in one patient. The highest incidence of infection occurred in late autumn and winter. All patients with T. mentagrophytes and T. verrucosum infections came from the same geographical area and the same climatic conditions.

Figure 8.
Presence of large spores on the surface of the hair (light microscope, magnification ×400) (courtesy of Honorata Kubisiak-Rzepczyk).

Figure 9.
Epidermal scales-hyphae in direct preparation (light microscope, magnification ×400) (courtesy of Honorata Kubisiak-Rzepczyk).
4. Discussion
The first cases of T. verrucosum from cattle were reported in 1959 in the United States in a group of dairy workers from Chicago [38]. Fungal skin infections in humans constitute an important clinical problem in some countries. The prevalence of dermatophytoses is diverse and depends on many factors, such as the socio-economic and sanitary conditions, increasing migration, development of tourism, immunological competence of the host and pathogenicity of the infectious agent, as well as the availability of medical resources and treatment [39]. The estimated data indicate that dermatophytosis affects over 20–25% of the world’s population [40]. Ringworm in cattle is highly contagious for breeders, veterinary doctors and veterinary technicians, as well as farm workers and employees transporting animals [41]. The main reservoir of T. verrucosum is cattle, and the fungus is rarely transmitted by other animals such as dogs, pigs, sheep, cats, goats and horses [42]. Cattle of all ages can be asymptomatic carriers of T. verrucosum and T. mentagrophytes. However, the occurrence of asymptomatic carriers of both dermatophytes is significantly higher in young animals under the 6th month of age [13]. Infection is facilitated by easy, direct contact with animals and microinjuries to the skin. Dermatophytes penetrate hair follicles and the stratum corneum, digest keratin and produce hyphae and conidia.
Our study showed that half of the patients were under 16 years of age. It is worth noting that in the study population, as many as 37.5% of children were under 6 years old. Failure to comply with the hygiene rules by adults in direct contact with the animals and the immediate environment was probably an indirect route of infection in young children. Some parents carried their children into the barn, where they could become directly infected. Similar cases of dermatophytosis in young children caused by being around cattle or playing in the cattle barn have been described by other authors [43,44]. The older children were often in the vicinity of cattle in the cowshed and outside them. The second largest group of the patients were adults directly associated with cattle breeding. In the study group, the most common sites of T. verrucosum infection and the only case of T. mentagrophytes infection were various areas of the trunk, followed by the head and upper and lower limbs. In children, the most common location of lesions was the head, and in adults, it was the upper limb. The clinical image of skin lesions caused by both pathogens is similar; however, in the case of T. mentagrophytes infection, the inflamed lesions usually affect the glabrous skin of the trunk and face, and the scalp less frequently [45]. In patients with primary and acquired immunodeficiency, dermatophytosis leads to the development of severe forms of disease, including extensive or invasive deep skin changes. The clinical manifestations of the infection may be nonspecific; lymph nodes and other organs may be affected [46,47,48,49].
The diagnostic standard of dermatophytosis is a direct microscopic examination and culture of material taken from fungus-affected skin or hair [50]. Some mycological laboratories for species identification use sensitive molecular methods [22,51]. The results obtained in this study showed that the direct microscopic examination allows for the identification of fungal hyphae and spores only in some patients. The diagnostic usefulness of the method is estimated at 90.5% [23]. Regardless of the light and fluorescence microscopy results, the fungal species were identified from the culture based on the characteristic appearance of hyphae and spores. In all patients, a skin infection with a specific dermatophyte was confirmed. The culture method is widely used for the diagnosis of fungi around the world [50]. Molecular methods used in diagnostics have a sensitivity of 76.7% [23]. Mycological diagnosis should be supplemented with a detailed professional and social interview, including holidays, free time and contact with cattle [42].
Vaccination programs implemented in many countries have proven effective and have contributed to low rates of infections in farm animals in central and northern Europe. Infections caused by T. verrucosum are still relatively more common in southern Europe and Arab countries [52]. Dermatophytosis in cattle is most often self-healing and does not require antifungal therapy. The disease can leave permanent changes on the skin, which reduces its quality and use in industry [7]. The treatment of dermatophytosis in humans should be carried out under the strict supervision of a dermatologist who decides on the choice of a drug and evaluates its effects. A local treatment of mycosis of smooth and hairy skin with the use of antifungal preparations in the form of shampoos and ointments was carried out with all the patients included in the study. During and after the treatment period, all patients underwent regular, scheduled visits to the dermatology clinic. In no case was it necessary to use oral medications. Our experience has shown that compliance with medical recommendations results in the high effectiveness of a local treatment. Advanced and extensive skin lesions require the implementation of systemic therapy [33].
The presented article is a retrospective study. It used available information on the confirmed dermatophytosis from cattle. Taking into account the cattle population in Greater Poland, the number of illnesses among cattle breeders and their family members over the course of over six and a half years does not seem to be high. However, it may pose a significant health, social and economic problem for people affected by this disease.
So far, there have been few published works on T. verrucosum infections in cattle breeders in Poland, including those concerning the genomic variability of strains. This publication is the first study from Greater Poland concerning cattle-to-human superficial mycoses in this group of people.
5. Conclusions
Dermatophytosis in humans can be caused by direct contact with dermatophyte-infected cattle and elements of the animal environment, as well as indirectly due to non-compliance with hygiene rules. Skin changes in humans associated with cattle are more often diagnosed in small children and men directly engaged in cattle breeding. The dominant etiological factor of the superficial fungal skin infection associated with cattle is T. verrucosum, which mainly affects the scalp in children and upper limbs in adult men.
The preventive strategies to effectively control fungal infections in humans and cattle should include systematic epidemiological studies, hygiene practices, improved husbandry conditions and early treatment of infected animals and people. The vaccination of young calves has fundamental therapeutic and preventive importance.
Author Contributions
Conceptualization, M.P. and T.P.; methodology, M.P., H.K.-R. and T.P.; validation, M.P., H.K.-R. and T.P.; formal analysis, T.T.; investigation, M.P. and T.P.; resources, H.K.-R.; data curation, M.P. and T.P.; writing—original draft preparation, M.P.; writing—review and editing, H.K.-R. and T.P.; visualization, M.P. and T.T.; supervision, T.P.; project administration, M.P. All authors have read and agreed to the published version of the manuscript.
Funding
This research received no external funding.
Institutional Review Board Statement
The study was conducted in accordance with the Declaration of Helsinki and approved by the Bioethics Committee at Poznan University of Medical Sciences (KB—186/23, 1 March 2023). This is a retrospective study and does not bear the characteristics of a medical experiment.
Informed Consent Statement
Not applicable.
Data Availability Statement
Data are contained within the article.
Conflicts of Interest
The authors declare no conflicts of interest.
References
- Statista. Available online: https://www.statista.com/statistics/263979/global–cattle–population–since–1990 (accessed on 17 June 2024).
- List of Letter Codes for Cattle. Available online: https://www.bing.com/search?q=Wykaz+kod%C3%B3w+literowych+do+oznaczania+ras+byd%C5%82a&qs=n&form=QBRE&sp=–1&lq=0&pq=wykaz+kod%C3%B3w+literowych+do+oznaczania+ras+byd%C5%82a&sc=0–46&sk=&cvid=80A494889A3646FA8E6D8137EB2C78D4&ghsh=0&ghacc=0&ghpl=breeds (accessed on 1 June 2024).
- Statista. Available online: https://www.statista.com/statistics/1405768/poland–number–of–cattle–and–cows (accessed on 15 August 2023).
- Statistics Poland. Available online: https://stat.gov.pl/files/gfx/portalinformacyjny/pl/defaultaktualnosci/5508/5/25/1/poglowie_bydla_wedlug_stanu_w_grudniu_2023_r..pdf (accessed on 31 January 2024).
- Smith, M.B.; McGinnis, M.R. Chapter 82—Dermatophytosis. In Tropical Infectious Diseases: Principles, Pathogens and Practice, 3rd ed.; W.B. Saunders: Philadelphia, PA, USA, 2011; pp. 559–564. [Google Scholar] [CrossRef]
- Papini, R.; Nardoni, S.; Fanelli, A.; Mancianti, F. High infection rate of Trichophyton verrucosum in calves from Central Italy. Zoonoses Public Health 2009, 56, 59–64. [Google Scholar] [CrossRef] [PubMed]
- Hameed, K.; Riaz, C.F.; Nawaz, M.A.; Naqvi, S.M.S.; Gräser, Y.; Kupsch, C.; Pasquetti, M.; Rossi, L.; Molinar Min, A.R.; Tizzani, P.; et al. Trichophyton verrucosum infection in livestock in the Chitral district of Pakistan. J. Infect. Dev. Ctries. 2017, 11, 326–333. [Google Scholar] [CrossRef] [PubMed][Green Version]
- Maurice, M.N.; Kazeem, H.M.; Kwanashie, C.N.; Maurice, N.A.; Ngbede, E.O.; Adamu, H.N.; Mshelia, W.P.; Edeh, R.E. Equine Dermatophytosis: A Survey of Its Occurrence and Species Distribution among Horses in Kaduna State, Nigeria. Scientifica 2016, 2016, 6280646. [Google Scholar] [CrossRef]
- Łagowski, D.; Gnat, S.; Nowakiewicz, A.; Osińska, M.; Trościańczyk, A.; Zięba, P. In search of the source of dermatophytosis: Epidemiological analysis of Trichophyton verrucosum infection in llamas and the breeder (case report). Zoonoses Public Health 2019, 66, 982–989. [Google Scholar] [CrossRef]
- Kuttin, E.S.; Alhanaty, E.; Feldman, M.; Chaimovits, M.; Müller, J. Dermatophytosis of camels. J. Med. Vet. Mycol. 1986, 24, 341–344. [Google Scholar] [CrossRef]
- Robi, D.T.; Mossie, T.; Temteme, S. Eukaryotic Infections in Dairy Calves: Impacts, Diagnosis, and Strategies for Prevention and Control. Vet. Med. Res. Rep. 2023, 14, 195–208. [Google Scholar] [CrossRef] [PubMed]
- Radostits, O.M.; Gay, C.C.; Hinchcliff, K.W.; Constable, P.D. Veterinary Medicine: A Textbook of the Diseases of Cattle, Horses, Sheep, Pigs and Goats, 10th ed.; Elsevier Saunders: London, UK, 2007; pp. 966–994. [Google Scholar]
- Agnetti, F.; Righi, C.; Scoccia, E.; Felici, A.; Crotti, S.; Moretta, I.; Moretti, A.; Maresca, C.; Troiani, L.; Papini, M. Trichophyton verrucosum infection in cattle farms of Umbria (Central Italy] and transmission to humans. Mycoses 2014, 57, 400–405. [Google Scholar] [CrossRef]
- Woodfolk, J.A. Allergy and dermatophytes. Clin. Microbiol. Rev. 2005, 18, 30–43. [Google Scholar] [CrossRef]
- Guo, Y.; Ge, S.; Luo, H.; Rehman, A.; Li, Y.; He, S. Occurrence of Trichophyton verrucosum in cattle in the Ningxia Hui autonomous region, China. BMC Vet. Res. 2020, 16, 187. [Google Scholar] [CrossRef]
- Courtellemont, L.; Chevrier, S.; Degeilh, B.; Belaz, S.; Gangneux, J.P.; Robert–Gangneux, F. Epidemiology of Trichophyton verrucosum infection in Rennes University Hospital, France: A 12–year retrospective study. Med. Mycol. 2017, 55, 720–724. [Google Scholar] [CrossRef]
- Lund, A.; Bratberg, A.M.; Næss, B.; Gudding, R. Control of bovine ringworm by vaccination in Norway. Vet. Immunol. Immunopathol. 2014, 158, 37–45. [Google Scholar] [CrossRef] [PubMed]
- Singh, I.; Kushwaha, R.K. Dermatophytes and related keratinophilic fungi in soil of parks and agricultural fields of uttar pradesh, India. Indian J. Dermatol. 2010, 55, 306–308. [Google Scholar] [CrossRef] [PubMed]
- Zienicke, H.; Korting, H.C. Intrafamilial transmission of Trichophyton verrucosum to a newborn. Mycoses. 1989, 32, 411–415. [Google Scholar] [CrossRef]
- Roman, C.; Massai, L.; Gianni, C.; Crosti, C. Case reports. Six cases of infection due to Trichophyton verrucosum. Mycoses 2001, 44, 334–337. [Google Scholar] [CrossRef]
- Swai, E.S.; Sanka, P.N. Bovine Dermatophytosis Caused by Trychophyton verrucosum: A Case Report. Vet. World 2012, 5, 297–300. [Google Scholar] [CrossRef]
- Gnat, S.; Łagowski, D.; Nowakiewicz, A.; Dyląg, M.; Osińska, M.; Sawicki, M. Detection and identification of dermatophytes based on currently available methods—A comparative study. J. Appl. Microbiol. 2021, 130, 278–291. [Google Scholar] [CrossRef] [PubMed]
- Aboul–Ella, H.; Hamed, R.; Abo–Elyazeed, H. Recent trends in rapid diagnostic techniques for dermatophytosis. Int. J. Vet. Sci. Med. 2020, 8, 115–123. [Google Scholar] [CrossRef]
- Bednarski, M. Choroby Bydła Podstawy Diagnostyki i Terapii, 2nd ed.; Apra–Wetpress s.c.—“Lecznica Dużych Zwierząt”: Gdansk, Poland, 2015; pp. 283–287. [Google Scholar]
- Gnat, S.; Łagowski, D.; Nowakiewicz, A.; Trościańczyk, A.; Zięba, P. Infection of Trichophyton verrucosum in cattle breeders, Poland: A 40–year retrospective study on the genomic variability of strains. Mycoses 2018, 61, 681–690. [Google Scholar] [CrossRef] [PubMed]
- Araújo, C.R.; Miranda, K.C.; Fernandes Ode, F.; Soares, A.J.; Silva Mdo, R. In Vitro susceptibility testing of dermatophytes isolated in Goiania, Brazil, against five antifungal agents by broth microdilution method. Rev. Inst. Med. Trop. São Paulo 2009, 51, 9–12. [Google Scholar] [CrossRef]
- Aly, M.M.; Bafiel, S. Screening for Antimicrobial Activity of Some Medicinal Plants in Saudi Arabia. In Proceedings of the World Conference on Medical and Aromatic, Cape Town, South Africa, 9–14 November 2008. [Google Scholar]
- Gołyński, M.; Lutnicki, K.; Kostro, K. Effect of Oral Administration of Zinc Sulphate with Simultaneous Use of Nonspecific Immunostimulation on the Course of Trichophytosis in Beef Cattle. J. Vet. Res. 2012, 56, 149–153. [Google Scholar] [CrossRef]
- Nisbet, C.; Yarim, G.F.; Ciftci, G.; Arslan, H.H.; Ciftci, A. Effects of trichophytosis on serum zinc levels in calves. Biol. Trace Elem. Res. 2006, 113, 273–280. [Google Scholar] [CrossRef] [PubMed]
- Pasa, S.; Kıral, F.; Kodu, Y. Serum zinc and vitamin A concentrations in calves with dermatophytosis. Kafkas Univ. Vet. Fak. Derg. 2009, 15, 9–12. [Google Scholar] [CrossRef]
- Değirmençay, S.; Eroğlu, M.S.; Kirbas, A.; Adiguzel, M.A. 25–Hydroxyvitamin D and Parathyroid Hormone Concentrations in Cattle with Dermatophytosis. Firat Univ. J. Health Sci. 2023, 37, 26–31. [Google Scholar]
- Hryncewicz–Gwóźdź, A. Dermatofitozy. Medycyna Praktyczna dla Lekarzy. 2023. Available online: https://www.mp.pl/interna/chapter/B16.II.18.142.1.1 (accessed on 10 August 2023).
- Nowicki, R.J.; Romaszkiewicz, A. Infekcje dermatofitowe. In Współczesna Dermatologia, 1st ed.; Rudnicka, L., Olszewska, M., Sar–Pomian, M., Rakowska, A., Eds.; Wydawnictwo Lekarskie PZWL: Warsaw, Poland, 2022; Volume 1, pp. 142–151. [Google Scholar]
- Pal, M. Dermatophytosis in an adult cattle due to Trichophyton verrucosum. Anim. Husb. Dairy Vet. Sci. 2017, 1, 1–3. [Google Scholar] [CrossRef][Green Version]
- Mikaili, A.; Chalabi, M.; Ghashghaie, A.; Mostafaie, A. Immunization against bovine dermatophytosis with live Trichophyton verrucosum. Afr. J. Microbiol. Res. 2012, 6, 4950–4953. [Google Scholar] [CrossRef]
- Lund, A.; Deboer, D.J. Immunoprophylaxis of dermatophytosis in animals. Mycopathologia 2008, 166, 407–424. [Google Scholar] [CrossRef]
- Abo–Elyazeed, H.; Soliman, R.; Hassan, H.; El–Seedy, F.R.; Aboul–Ella, H. Development, preparation, and evaluation of a novel non–adjuvanted polyvalent dermatophytes vaccine. Sci. Rep. 2023, 13, 157. [Google Scholar] [CrossRef]
- Ortiz, D.A.; Ren, P. Answer to July 2019 Photo Quiz. J. Clin. Microbiol. 2019, 57, 801–818. [Google Scholar] [CrossRef]
- Lee, Y.W.; Yun, S.J.; Lee, J.B.; Kim, S.J.; Lee, S.C.; Won, Y.H. Clinical and mycological studies on dermatomycosis (2001–2010). Korean J. Mycol. 2013, 18, 30–38. [Google Scholar]
- Havlickova, B.; Czaika, V.A.; Friedrich, M. Epidemiological trends in skin mycoses worldwide. Mycoses 2008, 51, 2–15. [Google Scholar] [CrossRef]
- Wagdy, R.E.; Mohamed, E.A. Identification of different Dermatophytes isolated from cattle, cats and horses suffered from skin lesions. Alex. J. Vet. Sci. 2016, 49, 126–132. [Google Scholar] [CrossRef]
- Schumny, U.; Wiegand, C.; Hipler, U.C.; Darr–Foit, S.; Peckruhn, M.; Uhrlaß, S.; Nenoff, P.; Elsner, P. Occupational Trichophyton verrucosum infection in a cattle farmer. Hautarzt 2020, 71, 899–902. [Google Scholar] [CrossRef] [PubMed]
- Jiang, Y.; Zhan, P.; Al–Hatmi, A.M.S.; Shi, G.; Wei, Y.; van den Ende, A.H.G.G.; Meis, J.F.; Lu, H.; de Hoog, G.S. Extensive tinea capitis and corporis in a child caused by Trichophyton verrucosum. J. Med. Mycol. 2019, 29, 62–66. [Google Scholar] [CrossRef]
- Maslen, M.M. Human cases of cattle ringworm due to Trichophyton verrucosum in Victoria, Australia. Australas. J. Dermatol. 2000, 41, 90–94. [Google Scholar] [CrossRef]
- Švarcová, M.; Větrovský, T.; Kolařík, M.; Hubka, V. Defining the relationship between phylogeny, clinical manifestation, and phenotype for Trichophyton mentagrophytes/interdigitale complex; a literature review and taxonomic recommendations. Med. Mycol. 2023, 61, myad042. [Google Scholar] [CrossRef] [PubMed]
- Rouzaud, C.; Hay, R.; Chosidow, O.; Dupin, N.; Puel, A.; Lortholary, O.; Lanternier, F. Severe Dermatophytosis and Acquired or Innate Immunodeficiency: A Review. J. Fungi 2015, 2, 4. [Google Scholar] [CrossRef]
- Lanternier, F.; Cypowyj, S.; Picard, C.; Bustamante, J.; Lortholary, O.; Casanova, J.L.; Puel, A. Primary immunodeficiencies underlying fungal infections. Curr. Opin. Pediatr. 2013, 25, 736–747. [Google Scholar] [CrossRef]
- Gega, A.; Ketsela, G.; Glavin, F.L.; Soldevilla–Pico, C.; Schain, D. Majocchi’s granuloma after antithymocyte globulin therapy in a liver transplant patient. Transpl. Infect. Dis. 2010, 12, 143–145. [Google Scholar] [CrossRef]
- Muñoz–Pèrez, M.A.; Rodriguez–Pichardo, A.; Camacho, F.; Rios, J.J. Extensive and deep dermatophytosis caused by Trichophyton mentagrophytes var. interdigitalis in an HIV–1 positive patient. J. Eur. Acad. Dermatol. Venereol. 2000, 14, 61–63. [Google Scholar] [CrossRef]
- Weitzman, I.; Summerbell, R.C. The dermatophytes. Clin. Microbiol. Rev. 1995, 8, 240–259. [Google Scholar] [CrossRef]
- Spanamberg, A.; Ravazzolo, A.P.; Araujo, R.; Franceschi, N.; Ferreiro, L. Bovine ringworm—Detection of Trichophyton verrucosum by SYBR–Green real–time PCR. Med. Mycol. Case Rep. 2023, 39, 34–37. [Google Scholar] [CrossRef] [PubMed]
- O’Gorman, S.M.; Britton, D.; Collins, P. An uncommon dermatophyte infection: Two cases of cutaneous infection with Trichophyton verrucosum. Clin. Exp. Dermatol. 2015, 40, 395–398. [Google Scholar] [CrossRef] [PubMed]
Disclaimer/Publisher’s Note: The statements, opinions and data contained in all publications are solely those of the individual author(s) and contributor(s) and not of MDPI and/or the editor(s). MDPI and/or the editor(s) disclaim responsibility for any injury to people or property resulting from any ideas, methods, instructions or products referred to in the content. |
© 2024 by the authors. Licensee MDPI, Basel, Switzerland. This article is an open access article distributed under the terms and conditions of the Creative Commons Attribution (CC BY) license (https://creativecommons.org/licenses/by/4.0/).









